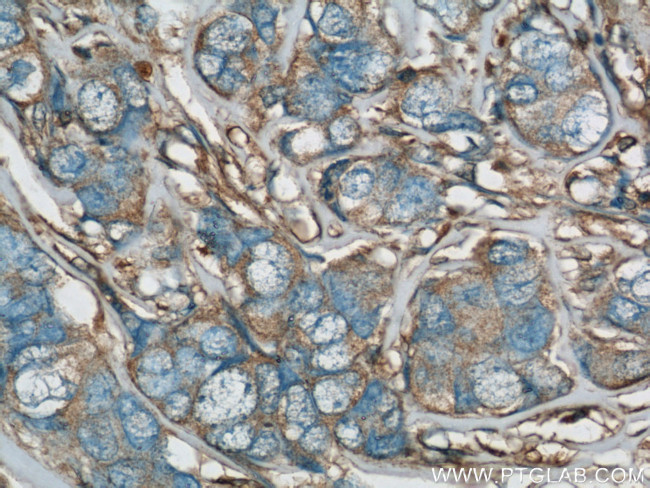
RhoGDI Antibody in Immunohistochemistry (Paraffin) (IHC (P))

Search
Proteintech
RhoGDI Polyclonal Antibody
{{$productOrderCtrl.translations['antibody.pdp.commerceCard.promotion.promotions']}}
{{$productOrderCtrl.translations['antibody.pdp.commerceCard.promotion.viewpromo']}}
{{$productOrderCtrl.translations['antibody.pdp.commerceCard.promotion.promocode']}}: {{promo.promoCode}} {{promo.promoTitle}} {{promo.promoDescription}}. {{$productOrderCtrl.translations['antibody.pdp.commerceCard.promotion.learnmore']}}
产品信息
10509-1-IG
种属反应
已发表种属
宿主/亚型
分类
类型
抗原
偶联物
形式
浓度
规格
纯化类型
保存液
内含物
保存条件
运输条件
产品详细信息
Immunogen sequence: MAEQEPTAE QLAQIAAENE EDEHSVNYKP PAQKSIQEIQ ELDKDDESLR KYKEALLGRV AVSADPNVPN VVVTGLTLVC SSAPGPLELD LTGDLESFKK QSFVLKEGVE YRIKISFRVN REIVSGMKYI QHTYRKGVKI DKTDYMVGSY GPRAEEYEFL TPVEEAPKGM LARGSYSIKS RFTDDDKTDH LSWEWNLTIK KDWKD (1-204 aa encoded by BC005851)
靶标信息
Aplysia Ras-related homologs (ARHs), also called Rho genes, belong to the RAS gene superfamily encoding small guanine nucleotide exchange (GTP/GDP) factors. The ARH proteins may be kept in the inactive, GDP-bound state by interaction with GDP dissociation inhibitors, such as ARHGDIA.
仅用于科研。不用于诊断过程。未经明确授权不得转售。
生物信息学
蛋白别名: ARHGDIA; epididymis secretory sperm binding protein Li 47e; GDI-1; GDP-dissociation inhibitor, aplysia RAS-related 1; MGC117248; Rho GDI 1; Rho GDI alpha; Rho GDP dissociation inhibitor (GDI) alpha; Rho GDP dissociation inhibitor (GDI) alpha isoform ARHGDIA_1; Rho GDP dissociation inhibitor (GDI) alpha isoform ARHGDIA_2; Rho GDP-dissociation inhibitor 1; Rho-GDI alpha; unnamed protein product
基因别名: 5330430M07Rik; ARHGDIA; C87222; Gdi-1; Gdi1; GDIA1; HEL-S-47e; NPHS8; Rho-GDI; RhoDGI; RHOGDI; RHOGDI-1
UniProt ID: (Human) P52565, (Mouse) Q99PT1
Entrez Gene ID: (Human) 396, (Mouse) 192662